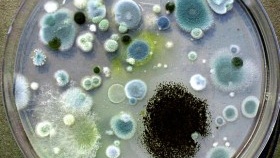

Причината за появата на гъбички в къщата е увеличаването на застоялата влажност. Достатъчно е да се счупи вентилацията при ремонт на апартамент и по стените се появяват малки петна, които след това се сливат. Мухълът прониква дълбоко в слоя мазилка и го разрушава. Спорите се разнасят във въздуха и причиняват различни заболявания, особено при децата. Ако имате влажен апартамент, засегнат от гъбички, не се отчайвайте. Всеки проблем може да бъде решен. Основното нещо е да знаете как.

За да унищожите гъбичките по стените, ще ви трябва:
- шпатула или твърда четка;
- ролка;
- въздушен нагревател;
- гипс;
- замазка;
- състав за премахване на следи от цимент и гипс;
- антисептичен разтвор;
- акрилатен антисептичен грунд;
- запечатващ разтвор;
- топлоизолационна боя.
Процедурата за извършване на работа по дезинфекция на стени.
- Извършете премахването на гъбичките през лятото, в горещо и сухо време. Не забравяйте да изсушите повърхността, която ще обработвате. За да направите това, можете да използвате вентилатор или сешоар.
- Отстранете тапетите или декоративните покрития от стените. Отстранете гипса от засегнатите места. Опитайте се да премахнете колкото е възможно повече, тъй като мицелът на плесента често се разпространява далеч отвъд видимата лезия. Използвайте шпатула и твърда четка, за да почистите добре зидарията.
- За да отворите порите на тухлата, обработете зидарията със смес, за да премахнете следите от мазилка и цимент. Подсушете стената отново.
- Нанесете бактерицидно средство върху цялата стена с помощта на валяк. Използвайте специални антисептични разтвори, за разлика от народните средства, те могат да се борят с различни видове гъбички, плесени и патогенни бактерии. Средства, познати на домакините, като урея или витриол, убиват един вид гъбички и създават благоприятна среда за други.
- Грундирайте стената с антисептичен акрилатен грунд. Това е необходимо, за да се отстрани прахът от стената и да се увеличи нейната адхезия.
- Нанесете хидроизолационен разтвор върху цялата повърхност на стената с помощта на валяк или широка четка, за да предотвратите по-нататъшно проникване на влага в слоя мазилка. След като хидроизолацията изсъхне, обработете стената отново с антисептичен грунд.
- Стената вече е готова за шпакловка. Когато мазилката изсъхне, обработете я със специална топлоизолационна боя. След това стената трябва да бъде измазана и добре изсушена.
- Едва след окончателното изсъхване върху обработените повърхности може да се нанесе декоративно покритие: залепете тапети, керамични плочки или монтирайте стенни панели.
Полезни съвети
Ако живеете в частна къща, не забравяйте да обработите външната част на къщата с хидрофобни материали. Такава работа в града трябва да се извършва от служители на управлението на вашата къща.
Често причината за влага в стената е неизправност на дъждовния канал от покрива. В този случай си струва да съберете собствениците на няколко апартамента и да изискате проблемът да бъде решен.
Как да се отървете от мухъл, гъбички в апартамента с народни средства
Хората отдавна се борят с мухъла. Ефектът е различен. Понякога положително.Но ако преди хората се интересуваха само от естетическата страна на проблема: мухълът изглежда грозен и влошава външното възприятие на стаята, сега учените са доказали абсолютната опасност и опасност от мухъл за здравето на човека. Разнообразие от болести очакват човек, ако живее в стая с мухъл и яде мухлясала храна. Помислете как можете да се отървете от мухъл, гъбички или поне да намалите броя им около нас, да подобрите качеството на живота ни.
видове форми
Мухълът е жива гъба, която расте като разклонен мицел. Мухълът понякога е полезен.
- Aspergillus niger се използва за производство на сладки вещества и лимонена киселина, както и витамин B2 (рибофлавин). Но в естествени условия Aspergillus niger е най-опасната черна плесен за здравето на хората и животните. Точно това виждаме във влажните ъгли на помещенията, под старите плочки на банята, в мазето, бараката, гаража и др. Във фазата на плододаване тази гъба разпръсква спори, които навлизат в дихателните ни органи и тровят тялото ни. Понякога черна плесен расте и по хляба.
- Botrytis cinerea, в своята несъвършена фаза, се използва за производство на вино, особено шери. Тази гъба дори се нарича благородно гниене, защото помага за създаването на суровини с високо съдържание на захар. Botrytis cinerea е известна като сива плесен. Той расте и по стените на стаи, особено дървени, но предпочита да се заселва върху живи растения. Ако ягодите или доматите са започнали да гният във вашата градина, най-вероятно са били поразени от сива плесен.Тази плесен не е толкова опасна, колкото черната плесен, но също така не си струва да вдишвате нейните спори или да ядете храни, засегнати от Botrytis cinerea.
- Penicillium също се счита за благородна плесен, използвана за производство на сирене. Сиренето е надупчено със синьо-зелени спори от тази гъбичка или покрито с кора от тази плесен. Антибиотикът пеницилин също се произвежда от Penicillium. Те лекуват възпаление. Но когато тялото е отслабено, тази гъба също може да се засели там, причинявайки различни заболявания, някои от които фатални. Penicillium се отлага главно върху продуктите. Следователно, за дългосрочно съхранение, те се стерилизират, варят и т.н. Понякога се появява върху дървени повърхности в къщата, особено ако са влажни.
- Има и бяла плесен. Използва се и за направата на сирене. Но тя може да живее в апартамент. Той също трябва да бъде унищожен, въпреки че не е толкова опасен за здравето, колкото горните видове.
- Обикновеният квас също е плесен. Въпреки че активно ги използваме за храна, много учени смятат, че това също е нездравословно.
Мухъл в апартамента. Какво да правя?
Както казахме, най-опасната в апартамента е черната плесен. Затова най-често във форумите хората питат, как да се лекува черна плесен. Тази плесен е много опасна. Затова първо се отстранява внимателно от стените, като се предпазват дихателните органи с респиратор или марля, за да не се вдишват спорите. Това се нарича механично отстраняване. След това повърхността трябва да се третира, например, с меден сулфат, разреден формалин или смес от калиева стипца, железен сулфат и готварска сол.Химическата обработка може да се извърши и с пламтяща сяра. Продуктите от изгаряне на сяра убиват всички възможни гъбички.
Мухълът в дървена къща може да бъде унищожен с креозот. Но помещенията, в които живеят хората, не се третират поради силната миризма. Ако по стените има мухъл и те са дървени, може да се намажат с олио. Но това не винаги е практично, когато откриете мухъл по пода или мебелите. След това можете да настържете сапун за пране, смесете с урина, настоявайте за сместа за един ден, след което избършете дървото. След това трябва да изплакнете, в противен случай ще продължи да мирише. Мухълът в килера може да бъде унищожен по същия начин. От древни времена хората са знаели начини за борба с мухъла по дървените повърхности, тъй като първоначално всички къщи са били направени от дърво.
урина, настоявайте за сместа за един ден, след което избършете дървото. След това трябва да изплакнете, в противен случай ще продължи да мирише. Мухълът в килера може да бъде унищожен по същия начин. От древни времена хората са знаели начини за борба с мухъла по дървените повърхности, тъй като първоначално всички къщи са били направени от дърво.
Ако има мухъл по стените и те не са дървени, можете да използвате сол Бишофит.
Понякога се среща мухъл върху тапета. Как да се борим не винаги е ясно. В крайна сметка тапетите ще загубят външния си вид, ако бъдат обработени с нещо. По-добре е да направите ремонт и да смените тапета, след като намокрите стените с биоцид.
Ако имате бяла плесен, нашата статия също ще ви каже как да се справите с нея. Бялата плесен често се появява в саксиите и след това засяга целия апартамент.Въпреки че не е толкова опасна за здравето, колкото черната, е необходимо да се отървете и от бялата плесен. Можете да използвате същите инструменти като за контрол на черната плесен. Ако мухълът е в мазето, където се съхраняват зеленчуците, можете да поставите кутия с негасена вар там. Добър за убиване на гъбички.
Понякога в саксиите или в аквариума се появява зелена плесен. Освен това е вредно. Как да се отървете от зелената плесен, хората също знаят от дълго време. Могат да се прилагат всички горепосочени методи. Все пак трябва да се помни, че химикалите са най-надеждните в борбата срещу всякакъв вид мухъл. Те могат да бъдат закупени в специализиран магазин. Ако искате бързи и надеждни резултати, свържете се с професионалистите. Особено ако мухълът е заразил големи площи от дома ви.
Добър начин за предотвратяване на мухъл е да проветрявате стаята, да изсушавате нещата, включително храната. Имаме нужда от бърз ремонт на авариралия водопровод. Водните капки водят до образуване на влага. Мухълът обикновено се развива на тъмни, непроветриви, топли и влажни места. Мухълът рядко живее на сухи, добре осветени места. Ето защо този вид превенция срещу образуването на мухъл ще ви спести време, пари и нерви.
Още начини да се отървете от петна от ръжда по тавана













Ако вече имате мухъл или гъбички, ще бъде по-безопасно да се обърнете към професионалисти, те ще ви предложат най-доброто решение.
Слава богу, че съм далече от този проблем, но кумът го имаше в спалнята, така че, макар и индиректно, и аз се сблъсках с него. Опитахме се да излезем заедно. Първоначално мухълът се появи върху тапета и през май изкъртихме напълно тапета от тази стена, но мухълът се оказа и на стената. Изкъртиха го с шпатула, кумата пак го изми с някаква сол, след като стените изсъхнаха, напръскаха го със спрей против гъбички, след което отново залепиха тапетите. И септември тази стена беше изолирана и досега мухълът не се е върнал.